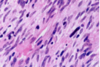

Images, etiologies, and treatments (random order) Flashcards
(1169 cards)
What is this clinical presentation?

Geographic tongue/
areata migrans
What is this infectious disease?

Oral Verruca Vulgaris
HPV 2,4,6
Also “finger‐like
projections”
remember it’s contagious
What is this radiographical finding?

Metastatic Carcinoma to Jaw Bones
C. Periapical image of a metastatic lesion of breast carcinoma; note the irregular widening of the periodontal membrane spaces and patchy sclerotic bone reaction, especially around the roots of the molars
Histoplasmosis
is endemic where
who can get infected by it?
How does is spread?
● Endemic in fertile river valleys
‐ Seen in people who spend a lot of time outside; near Ohio and Mississippi rivers
● Bird and bat excrement
● Airborne spores enter lungs through inhalation
● Macrophage ingests fungusàT‐lymphocyte immunity
● Antibodies develop several weeks later
● Macrophages may confine fungus (express disease later)
Sickle Cell Anemia Types and which is resistant to malaria?
- Sickle cell trait ‐ one allele is affected, only 40‐50% of hemoglobin will be abnormal, no significant clinical manifestations
- Sickle cell disease ‐ both alleles affected, close to 100% of hemoglobin is abnormal, significant clinical problems
▪ Abnormal gene confers resistance to malaria, therefore, sickle cell trait is seen most frequently in populations from areas endemic for malaria (Africa, the Mediterranean, and Asia)
Leprosy is also known as ———
Hansen disease
Which systemic disease manifests like this?

Crohn Disease
- Patients can also get angular cheilitis
- Above the Linear ulceration, can see a flap like structure which is the hyperplastic margin
Is this Globulomaxillary Cyst , lateral granuloma or OKC?

~ it is kind of a teardrop or pear shaped size
~Little less well differentiated in this particular instance but again unilocular radiolucency between the roots of two teeth
This one ended up being an OKC
What is this disease?

Simple Bone Cyst
Also known as
1.) Solitary Bone Cyst.
2.) Traumatic Bone Cyst.
3.) Idiopathic Bone Cyst.
4.) Hemorhhagic Bone Cyst.
Remember radiographic feature
tend to Scalop between teeth
Treatment includes surgical curettage- spontaneous healing has been reported.

Infantile
Hemangioma
When do they appear?
Rate of Development
Clinical presentation
Treatment
- When do they appear? They are rarely present at birth, infants are Born with this in place.
- Rate of development: the tumor will demonstrate rapid development that occurs at a faster pace than the infant’s overall growth in the first few weeks of life,
- Treatment: Typically will involute with time, Some cases don’t involute, so need to be removed
- It is a vascular Anomaly
Crohn Disease
Treatment
- Current strategies aim for deep and long‐lasting remission, with the goal of preventing complications, such as surgery, and blocking disease progression
- Immunosuppressant such as cyclosporine
- In more severe cases;
- *high dose corticosteroids and**
- chemotherapeutics to induce a remission
-
Nutritional supplements (iron, folate)
- Because they are unable to absorb nutrients
- If medical means do not keep patient under control► surgical removal of a portion or all of the intestine
- When intestinal symptoms are under control►oral ulcerations resolve
What is the radiographical finding?

“Primordial” Cyst
Assuming histologically it is different from OKC
Cryptococcus can cause what kind of infections?
● Pulmonary infection
● Meningitis ( after it spreads from the lungs to the brain. )
What is “Sulfur granules”
Where it is found?
In which infection?
color?
colonies of bacteria (o Actinomyces israelii
o Actinomyces viscosus)
found in suppuration (pus) which means Suppuration (pus) is dead tissue, bacteria, dead white blood cells, and other products of tissue breakdown..
Sulfur granules found in Actinomycoses
yellow in color
Erythematous
Candidiasis
what are its
Clinical finding?
Subtypes?
● Clinical Findings:
- Red macules or patches
- Can be due to multiple things
● Subtypes:
‐ Atrophic Candidiasis (acute‐feels like mouth has been scalded)
‐ Median Rhomboid Glossitis (asymptomatic)
‐ Denture Stomatitis (asymptomatic)
■ HAS THE SHAPE OF THE DENTURE
‐ Chronic multifocal (asymptomatic)
■ THIS HAS BEEN THERE FOR A LONG TIME
What is the radiographic finding?

Residual Cyst
What is this clinical finding?

Branchial Cleft Cyst
Then you can see it in an older person; this is getting
to be maybe 4-5 centimeters at least in size. He left
his for a little bit longer
If you see Condyloma Acuminatum in a child, what is the next step?
-Since this is a sexually transmitted disease, we need to suspect sexcual child abuse and investigate further!
Monomorphic Adenomas
What is it?
Types?
Treatment?
What is it?
Proliferation of 1 type of cell makes up the tumor.
Types? Includes:
o Canalicular Adenoma
o Basal Cell Adenoma
Treatment for all monomorphic adenomas is surgical excision & diagnosis is done with biopsy
What are the Constant bacterial species found in Necrotizing Periodontal Diseases?
Will we be able to use microbiological testing to form a diagnosis?
o Treponema spp.
o Selenomonas spp.
o Fusobacterium spp.
o Prevotella intermedia
o *Also always present in healthy gingiva ▪ so, No, Microbiological testing is NOT used to form a diagnosis
What is this infectious disease?

Necrotizing Gingivitis (NG)
o No periodontitis features
o SIMILAR APPEARANCE to gonorrhea
▪ Distinguishing characteristic of NG – Fetid Odor
What is this clinical finding?

Sublingual Varices
What is this gross finding?

Grossly image of
Dentigerous Cyst
What is the radiographical finding?

Odontogenic
Keratocyst
OKC